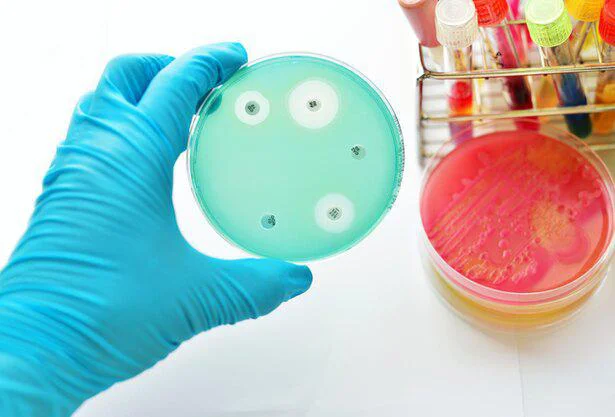

偶然から発見された抗生物質「ペニシリン」 誰かに話したくなる地球の雑学(87)
日本の裏側は本当にブラジル!? フグが自分の毒で死なないのはなぜ? きっと誰かに話したくなる理系のウンチクを、『人類なら知っておきたい 地球の雑学』から1日1本お届け!
◇◇◇
偶然から発見された抗生物質「ペニシリン」
肺炎や梅毒などから、多くの人間の命を救ってきたのが抗生物質のペニシリンである。この抗生物質は、偶然に、それも失敗した実験を契機に発見された。
1928年、イギリスの細菌学者フレミングは、ブドウ球菌を培養していたシャーレの中に青カビが生えているのに気がついた。どこからか青カビの胞子が飛んできて、そこに入り込んでしまったのだ。シャーレの中に異物を混入させるなど、細菌学者としては初歩的なミスである。しかも培養の途中で、フレミングは家族旅行に出かけて研究室を留守にしていたのだ。
だがフレミングは、青カビの周囲だけブドウ球菌が繁殖していないことを不思議に思って研究を進め、カビがつくり出す化学物質のペニシリンが細菌の生育を妨げる抗生物質だとの論文を発表した。だが、この論文はあまり注目されず、しかも、ペニシリンを精製するのは困難だったため、フレミングはそれ以上の研究をあきらめた。
しかし1940年になって、オックスフォード大学の研究者、エルンスト・チェーンとハワード・フローリーがペニシリンの抽出に成功する。
そして第二次世界大戦では、負傷兵の治療のため大量のペニシリンが必要になった。負傷した兵士たちは、化膿した傷口から細菌が入ったことによる敗血症で命を落とすことが多かったのだ。
感染を防ぐ医薬品開発は国家の緊急課題となり、イギリスとアメリカはペニシリン研究を国家機密に指定すると、巨額の研究資金を投入した。こうしてペニシリンは大量生産が可能になり、一般にも広く用いられるようになったのである。
戦争が終結した1945年、フレミング、チェーン、フローリーの3人は、ノーベル生理学・医学賞を受賞した。そしてペニシリンは戦後の日本でも用いられ、それまで40歳代だった平均寿命を押し上げる要因の一つになったのである。
著=雑学総研/「人類なら知っておきたい 地球の雑学」(KADOKAWA)
Information
おすすめ読みもの(PR)
プレゼント応募

「「ノザキのコンビーフ(80g×6 個)」」
そのままでも調理してもおいしいから、ローリングストックに最適!
メルマガ登録で毎週プレゼント情報が届く!
新規会員登録する
読みものランキング
読みものランキングをもっと見る
レシピランキング
レシピランキングをもっと見る
レタスクラブ最新号
レタスクラブ最新号詳細